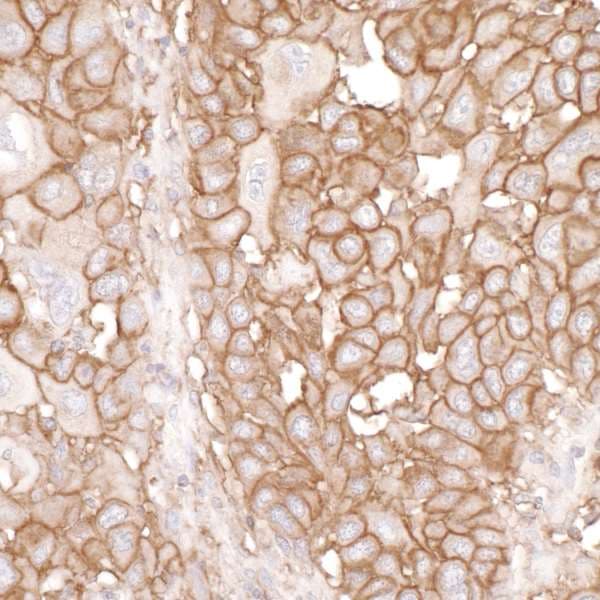
Anti-CD44 antibody(AB157107)

Anti-CD44 antibody(AB157107)
$undefined

Same trusted quality, new lower price
| Shipped At Conditions | Blue Ice |
| Appropriate Long term Storage Conditions | Store at +4°C. |
| Clonality | Polyclonal |
| Applications | IHC-P, IP, WB |
| Species Reactivity | Human, Mouse, Rat |
| Isotype | IgG |